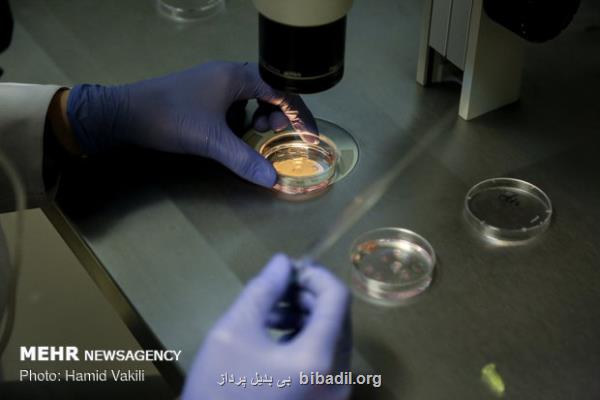

برای ارزیابی توده سلولی؛
بی بدیل پرداز: پژوهشگاه رویان اعلام نمود حیوان مدل آزمایشگاهی تراریخته برای ارزیابی توده سلول های بتا ساخته شد.
به گزارش بی بدیل پرداز به نقل از پژوهشگاه رویان، از دست رفتن توده سلول های بتا یکی از خاصیت های اصلی دیابت نوع یک و یکی از علایم دیابت نوع دو پیشرفته است. درک ساز و کار تخریب و بازسازی توده سلول های بتا برای تحقیقات پیش بالینی دیابت ضرورت دارد. بنا بر این اندازه گیری توده سلول های بتا در تحقیقات دیابت حائز اهمیت می باشد. از ین جهت، روش های مختلفی برای ارزیابی و اندازه گیری توده سلول های بتا به وجود آمده است که بیشتر آنان وقت گیر و دشوار یا نیازمند ابزارهای تصویر برداری خاصی است. یکی از روش های بررسی توده سلول های بتا استفاده از مدلهای حیوانی تراریخته است. مدلهای حیواتی تراریخته متفاوتی به وجود آمده اند که می توانند پروتئین فلورسانت سبز را تحت کنترل آغازگرهای ویژه سلول های بتا مانند آغازگر انسولین، بیان کنند. این مدلها نیاز به رنگ آمیزی و ردیابی سلول های بتا را از بین می برند اما برای جلوگیری از تهیه حجم زیادی از برش های بافت شناسی، یک روش تشخیص پائین دست مکمل نیز لازم است. یکی از روش هایی که برای پاک سازی لیپیدها از بافت فلورسانت استفاده می شود، شستشوی آن با سدیم دودسیل سولفات است. این روش که پاکسازی سریع بافت بدون آکریلامید (FACT) نامیده می شود امکان تصویر برداری ترنس لوسنت از بافت فلورسانت را فراهم می آورد. دکتر یاسر تهمتنی، فاطمه کرمی، بهروز عسگری آبی بیگلو، ساغر پهلوان نشان، امین تمدن و همکارانشان در پژوهشگاه رویان، دانشگاه علوم پزشکی شهید بهشتی و دانشگاه علوم پزشکی بوشهر با بهره گیری از این تکنولوژی های جدید یک مدل حیوانی تراریخته برای ارزیابی توده سلول های بتا ایجاد کردند. مقاله انتشار یافته از این دست آورد پژوهشگران ایرانی در نشریه بین المللی BioImpacts، شرح می دهد تعداد جزایر لانگرهانس قابل شناسایی در این روش بیش از روش های مشابه است و پروتئین فلورسانس سبزی که در سلول های بتا بیان می شود امکان ارزیابی میزان از میان رفتن توده سلول های بتا را بسادگی فراهم می آورد. ساخت این مدل تراریخته آزمایشگاهی ابزار مناسبی برای پژوهش های بیشتر در حوزه دیابت برای پژوهشگران ایرانی فراهم نموده است و قدمهای مؤثر درباب غلبه بر این بیماری را تسریع می کند.
منبع: بی بدیل پرداز
تاریخ انتشار: 1401/12/01
زمان: 12:09:03
گروه: مطالب عمومی
بازدید: 779
امتیاز: 5.0
تازه ترین
مطالب مرتبط
نظرات بینندگان در مورد این مطلب